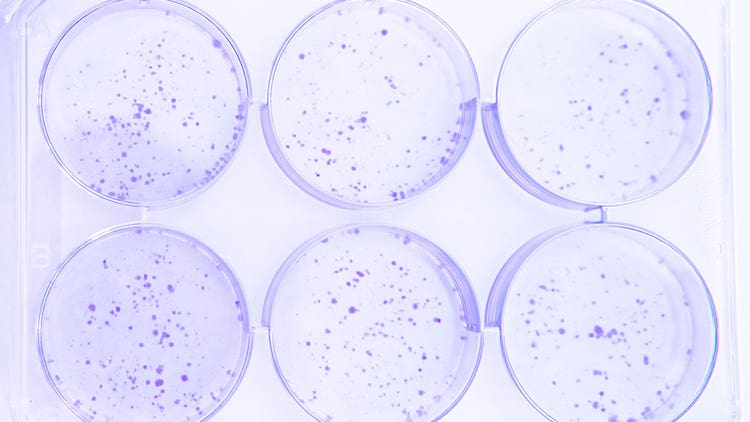

Stable cell lines are cellular models that harbor genetic modifications to express specific proteins or biomolecules of interest. Generating stable cell lines involves a sequential series of events intended to produce a uniform population of cells that homogeneously express the transgene.
The process of engineering stable cell lines commences with the design and construction of an expression vector which is then integrated into the genome of the host cell. Following this genetic modification, the cells undergo rigorous screening using various analytical assays to assess different parameters such as gene expression, protein production and cell viability. Finally, stable cell clones are selected based on the screening results and designated for further analysis and scale-up.
Stable cell lines have numerous downstream applications in various fields, including drug discovery, functional genomics and biomanufacturing. They have enabled the production of recombinant proteins, monoclonal antibodies, viral vectors for gene therapy, and the study of gene function and regulation in vitro.
The Basics of Cell Line Development
Therapeutic protein products are manufactured using cells derived from various sources, including bacterial, mammalian, insect and yeast cells. The selection of these cells is largely dictated by the expression of the target gene, which determines the suitability of a particular cell type for protein production. The optimal cell type is determined based on factors such as the expression level of the target protein, the post-translational modifications required and the downstream processing requirements. As such, selecting the appropriate cell type is a crucial step in the manufacturing process of biotechnology products.
The following types are examples of extensively used cells in research and pharmaceutical manufacturing processes.
- CHO Cells: The Chinese hamster ovary (CHO) cell line is highly productive and exhibits excellent growth in serum-free media. It is the preferred choice of manufacturers for producing antibodies and Fc fusion proteins due to glycosylation. Additionally, it has been approved for use in biopharmaceutical manufacturing by regulatory bodies.
- Human embryonic kidney (HEK293) cells: HEK293 cells are a commonly used cell line in biomedical research. They have been used to produce recombinant proteins, monoclonal antibodies and viral vectors for gene therapy.
- Baby hamster kidney (BHK) cells: This cell line is used by biopharmaceutical manufacturers for complex protein or vaccine production. These cells can attach sulfate residues to proteins which enhance their biological effectiveness. However, it is important to note that they may also attach immunogenic glycans, posing potential risks.
- Escherichia coli: E. coli is a popular choice for producing recombinant proteins in biopharma due to its simple genetic makeup, fast growth rate and cost-effectiveness. However, it cannot perform certain post-translational modifications.
- Sf9 Cells: This cell line is derived from Spodoptera frugiperda and utilizes a baculovirus expression system. Sf9 cells are a popular choice for producing recombinant proteins and viruses used in gene therapies. These cells are particularly useful for generating high titers of adeno-associated virus (AAV) serotypes. However, studies have shown that the post-translational modifications produced by these cells can pose clinical risks.
See how Danaher Life Sciences can help
Steps Involved in Stable Cell Line Generation
Here’s an overview of the steps involved in stable cell line generation protocol:
- Choose the expression system: A cell line or expression system is selected based on efficiency to produce the desired gene or protein. Selection is influenced by product modifications, critical quality attributes, titer and secretion.
- Choose a suitable vector: The delivery of a gene of interest to a host cell is facilitated by a vector system comprising promoter and regulatory elements. This system can use either a plasmid or viral vector, depending on the specific requirements of the experiment or application.
- Transfection or Transduction: The vector is inserted in the host cell using one of two methods. Transfection is introducing a vector into the host cell using physical or chemical means. When a viral vector is utilized to introduce a vector into a host cell, this process is referred to as transduction.
- Selection and screening of the successfully transfected cells: Various selectable markers and biomarkers, including metabolic selectable markers such as methotrexate (MTX ), as well as antibiotic selectable markers, are employed to select successfully transfected or transduced cell lines.
- Cloning and expansion of the selected cells: Cells selected for amplification are introduced into cultures in a controlled environment. Bioreactor systems are used for commercial production and cells are closely monitored. To ensure the generation of stable cell lines, the cell cultures are assessed based on parameters such as media analysis, protein sequence heterogeneity, glycosylation profile, clone stability, charge variants and growth dynamics, among others. This process produces the master cell bank used for product manufacturing.
Technologies and Tools Used in Stable Cell Line Generation
Different stages of stable cell line development involve different technologies and tools:
- Non-viral and viral-based delivery systems: Vectors act as a vehicle to transfer the gene of interest into the host cell for specific protein expression. The choice of vectors to generate a stable cell line depends on the type of target cells and the size of the target genetic material to be integrated into the vector. The types of non-viral vectors include plasmid vectors and oligonucleotides, whereas the viral vectors include viruses, such as lentivirus and adenovirus. Lentiviral vectors are popularly used in commercial settings to transfect cells to generate stable cell lines.
- CRISPR/Cas9 technology for targeted gene editing: The technique has opened the doors to target integration of genes of interest in the expression systems (such as CHO cells). They offer an effective approach for the consistent and stable expression of targeted genes. Partial chromosome loss or gene silencing is a known artifact.
- High-throughput screening and automation technologies: Generating a stable cell line is a multi-step process, starting from choosing an expressions system and ending with scale-up production. The process is time-consuming and labor-intensive, which can be overcome by using automation technologies or platforms.
- Data/Process Management Software: To handle large amounts of process data, advanced data management systems are required. Enterprise-level software can simplify the collection of in-process data and equipment metadata. Data management software also enables real-time data analysis, allowing swift process changes.
- Analytical systems: When generating stable cell lines, analytical instrumentation such as cell sorters, imaging systems, HPLC and mass spectrometry are used to collect important drug product and critical quality attributes.
Challenges and Considerations in Stable Cell Line Generation
Stable cell line generation offers several advantages, such as:
- Improved product batch-to-batch consistency
- Favorable growth profiles
- Application for numerous fields in research and biologics production
However, developing stable cell lines is a complex process with several challenges. The most significant challenge is the time it takes to complete the process. Developing a stable cell line can take up to 6-12 months from start to finish.
Furthermore, generating and maintaining stable cell lines requires a considerable amount of labor. It involves maintaining a sterile environment throughout the process, monitoring and characterizing cell lines, maintaining data integrity and conducting screening steps. All these steps require extensive effort to keep the cell lines healthy for use in research and biologics manufacturing processes.
Manufacturers must ensure data integrity and availability for regulatory filings, which involves monoclonality verification. Manual data processing can result in errors and delays in developing stable cell lines.
FAQs
What is stable cell line development?
Stable cell line development involves introducing and verifying the stable genetic integration, growth and expression of cell lines producing target proteins or biologics.
How long does it take to generate a stable cell line?
It can take 6-12 months to generate a stable cell line.
What are the advantages of stable cell lines?
Stable cell lines have several advantages, including reduced batch-to-batch variability, wide-ranging applications and favorable growth profiles.
What is the difference between a transient cell line and a stable cell line?
A transient cell line is a population of cells where the target genes are not integrated into the host genome. As a result, gene expression can only be observed for a short time. On the other hand, stable cell lines contain integrated genes within the host genome, allowing for long-term gene expression.
What is the process of a stable cell line?
Stable cell generation includes the following stages:
- Choosing a suitable expression system
- Transfecting host cells using a suitable vector
- Screening and characterizing transfected cells
- Single cell cloning
- Stable cell line and master cell bank generation
See how Danaher Life Sciences can help
Stable Cell Line Generation